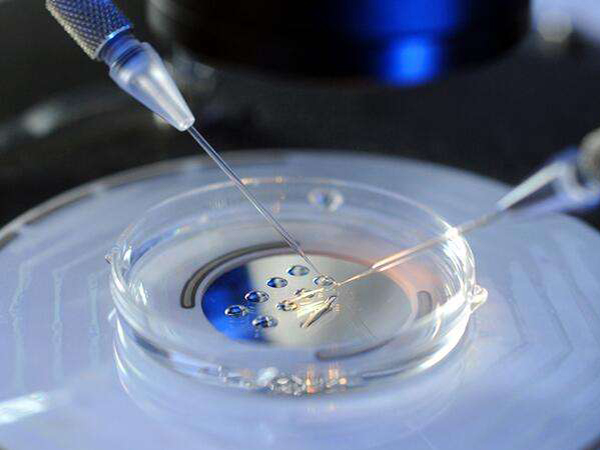

盘点四川三代试管成功率高的医院,真不用紧盯华西二院不放了
- 试管婴儿经验
- 2023-08-12 10:06
四川截止2020年卫健委发布的生殖医院名单来看,该省目前只有10家医院取得了开展试管婴儿助孕的合法资质,其中只有两家医院可以开展三代试管助孕,分别是四川大学华西第二医院和四川省妇幼保健院,其中华西二院知名度较高,因此很多人都去该院做三代试管,但是其实省妇幼的试管婴儿的综合实力也较强,成功率也高达50%以上。
四川省可以开展三代试管助孕的医院有两家
先怀孕,后付款-出生才是硬道理47岁1个卵泡一次成功经验分享不出国做三代-疫情下的试管新对策57岁供卵试管婴儿成功经验分享
助孕交流群
方法/步骤
四川省开展试管助孕的医院一直不多,知名度最高的医院莫过于四川大学华西第二医院,该院在试管方面拥有超过60%的高成功率,加上科目开设齐全,实验室设备十分先进,近些年吸引了很多的患者前来该院进行试管婴儿治疗。
华西二院可以开展三代试管助孕
在四川说起做三代试管婴儿很多人想到的都是华西第二医院,但是其实该省除了华西二院,还有一家医院也可以做三代试管医院,那就是四川省妇幼保健院,该院生殖中心在2019年获得三代试管助孕资质的,通过这两年的发展,该院试管拥有以下几点优势:
1、该院生殖中心开设科室全面,有不孕不育门诊、男科门诊、多囊卵巢综合征专病门诊、生殖内分泌门诊、试管婴儿周期门诊、试管婴儿咨询门诊、生殖遗传咨询门诊等常规门诊业务;
2、该院的生殖医学中心是四川省唯一生殖医学重点学科,在医生团队方面十分强大;
3、该医院生殖中心的成功率高达50%上,近两年稳定在60%左右;
4、卵子冷冻技术全省位居前列,而且该省首例冻卵双胎试管在该院诞生,试管临床经验十分丰富。
Tips:
以上就是四川省妇幼保健院的试管优势,在三代试管方面成功率高,设备先进,团队强大,而且近几年的门诊量也持续上升,拥有较高的口碑,所以在四川做试管婴儿真不用紧盯这华西二院不放,也可以考虑考虑四川省妇幼保健院。

发表评论